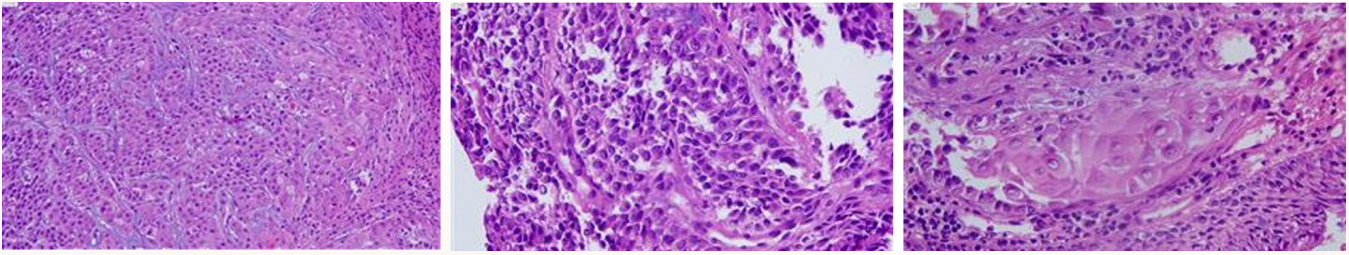

【病史】
患者为中年男性,主诉反复咳嗽、咳血4月,并伴气促1月。外院胸部CT显示气管管腔狭窄,纵隔区肿大淋巴结。支气管镜活检结果为角化性鳞状细胞癌(见下图)。患者既往无特殊病史及手术史。
【影像学检查】
*胸段气管肿瘤,长径约5.0cm,侵犯气管壁全层,管腔狭窄,与食管关系紧密;
*纵隔(4L组)高代谢淋巴结,未除外淋巴结转移。

【肺功能检查】
患者表现为极重度阻塞性肺通气功能障碍,F-V曲线显示呼吸双相流量下降,符合固定型大气道阻塞特征。
【支气管镜检】
气管中下段新生物,管腔重度狭窄,触之易出血,已进行支气管镜内镜治疗。

【MDT讨论】
01长段气管鳞癌的治疗选择
1. 保守治疗 vs 手术治疗
2. 直接手术 vs 新辅助治疗后手术
广州医科大学附属第一医院陈汉章主任指出,结合患者检查结果,考虑到直接手术的难度和可能的切除长度,建议先进行化疗联合免疫新辅助治疗,再进行手术。李树本教授补充,气管切除长度对患者预后有显著影响。针对国内患者的情况,尤其是合并糖尿病的女性患者,切除气管超过4厘米属于高风险。通过文献回顾,他提到2017年麻省总医院首次报道了气管鳞癌的新辅助免疫治疗应用[1]。经院际MDT讨论后,患者开始接受新辅助免疫治疗,经过两疗程后,CT评估为部分缓解(PR)。支气管镜检查确认气管病变的位置和侵犯范围。
02手术入路的选择
1. 开胸入路vs正中入路
2. 是否需要喉松解
李树本教授指出,喉松解一般是在颈段或颈胸交接部进行。对于胸段气管切除,喉松解通常不必要。根据手术需求,应选择正中入路进行双侧肺门和下肺韧带的松解。
03新辅助免疫治疗后
1. 气道吻合:连续 vs 间断缝合
2. 吻合口是否需要包埋
3. 包埋材料的选择
广西壮族自治区人民医院的医生建议,吻合口的缝合方式可根据具体情况选择。对于高张力吻合口,可使用背阔肌皮瓣等材料进行包埋,以保护吻合口并防止并发症。安徽医科大学附属第一医院的专家则认为,吻合口采用连续缝合,并通过气管和周围纤维结缔组织进行两层包埋。
【回顾文献】
研究表明,长段气管重建高张力吻合口术后易出现局部缺血、吻合口分离、断裂等严重并发症[2]。此外,也有研究表明用气道周围自体组织对吻合口进行保护性包埋,被认为是一种避免吻合口并发症发生的潜在方法[3]。本例患者因接受新辅助治疗,气管切除长度约为5厘米,建议使用间断缝合,并进行吻合口包埋。
根据本中心实践经验,选择胸大肌带蒂肌瓣对气管重建吻合口进行包埋:
①位于气管吻合口附近,易取材
②能较好地确切评估其血液供应支
③手术过程中不需改变体位
④可以修改宽阔的肌体来填充纵隔区域的空间
【术前准备与手术实施:】
在术前,超声多普勒评估了胸大肌肌瓣的血供。经整形外科协作,成功游离胸大肌,保留胸肩峰动脉,制备胸大肌带蒂肌瓣。术中采用正中入路,进行“Tubeless气管肿瘤切除 + 气道重建术”。通过非插管自主呼吸麻醉,实施气道重建,避免术野反复插管干扰,无需中断操作,吻合一气呵成。新辅助后高张力吻合口,采取胸大肌肌瓣-胸腺瓣联合包埋。

【术后管理】
“Guardian”stitch护理,颈托头枕,加压包扎胸壁,并进行发声和吞咽功能的恢复训练。
【病例小结】
本病例展示了新辅助治疗后进行复杂气道重建的可行性与安全性。Ⅱ期试验(GALAXY-01)初步研究结果表明,原发性气管鳞状细胞癌患者通过新辅助联合治疗,能够提高R0切除率和主要病理缓解率(MPR)。


该临床试验初步成果获2024 ESTS大会主题发言
【专家点评】
中日友好医院刘德若教授表示,气管切除长度的研究至关重要,尤其是在中国患者中,切除长度超过4厘米存在较高风险。他还强调,长段气管手术中松解处理很关键,特别注意心包打开后进行彻底松解两侧肺门。新辅助治疗对于气管鳞癌同样具有必要性,并强调包埋材料的选择应根据患者的具体情况来决定。
清华大学附属北京清华长庚医院陈东红教授总结认为,气管外科手术充满挑战,尤其是在确定气管切除长度时,切除长度与患者自身气管长度的比例关系应成为风险评估的重要参考。
【最后总结:】
本病例不仅为气管肿瘤的治疗提供了新思路,也为复杂气道重建术的安全实施积累了宝贵经验。Tubeless联合新辅助免疫治疗为未来气管肿瘤治疗提供了新的潜在策略。

参考文献:
[1] Osho AA, Azzoli CJ, Pai S, Mino-Kenudson M, Faquin WC, Huynh TG, Lanuti M, Mathisen DJ, Muniappan A. Successful Treatment of an Aggressive Tracheal Malignancy With Immunotherapy. Ann Thorac Surg. 2017 Feb;103(2):e123-e125.
[2] Wright C D, Grillo H C, Wain J C, et al. Anastomotic complications after tracheal resection: prognostic factors and management[J]. The Journal of Thoracic and Cardiovascular Surgery
[3] Grillo H C. Development of tracheal surgery: a historical review. Part 1: Techniques of tracheal surgery[J]. The Annals of Thoracic Surgery, 2003, 75(2): 610–619